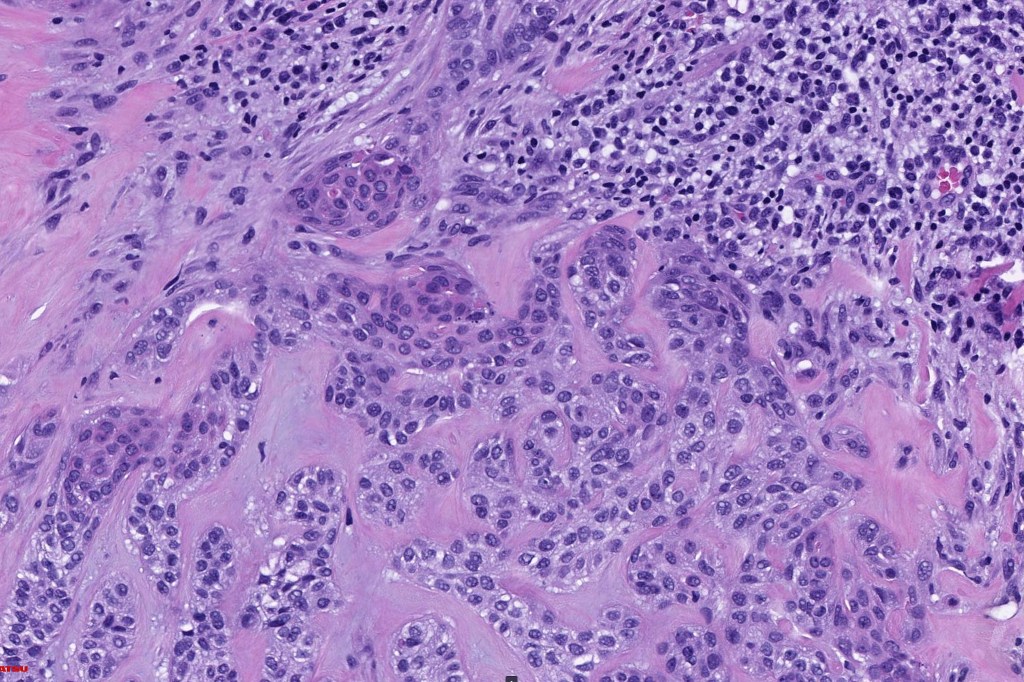

Trichilemmoma is a tumor showing differentiation towards the follicular external root sheath. It may be solitary, multiple or constitute a features of autosomal dominant, Cowden (multiple hamartoma) syndrome when very numerous lesions are present. The last is associated with germline mutations in the PTEN tumor suppressor gene in the majority of patients. Solitary lesions do not show this mutation, rather activating mutations in HRAS. Recently a subset has been identified displaying mutations in tyrosine phosphatase PTPN14 gene with or without a HRAS mutation (Eleanor Russell-Goldman et al 2022). In the past, some authors have suggested that trichilemmoma represents a verruca vulgaris variant but this has been largely discredited.
Trichilemmoma
Clinical features
•M>F
•Middle aged & elderly
•Head & neck with a predilection for the face & ears but may present elsewhere
•Flesh colored , erythematous or yellow/brown verrucous <1.0 cm papule or nodule
•Smooth surface or associated with a central crusted dell
•Keratin horn sometimes present
•Can arise in nevus sebaceus
•Cowden syndrome is very rare, and in addition to numerous trichilemmomas, patients can develop a range of other hamartomas including acral keratoses, punctate keratoses of palms & soles, hemangiomas, neurofibromas & schwannomas & gastrointestinal polyps (criteria for diagnosis are included in the table below)
•Breast fibrocystic disease & fibroadenomas
•Thyroid goiter & adenoma
•Macrocephaly
•Oral fibromas with a cobblestone appearance
•Increased risk of malignancy including breast, thyroid, endometrium & kidney
•Dysplastic cerebellar gangliocytoma (Lhermitte-Duclos disease) is pathognomonic of Cowden syndrome

Histologicla features
•Multilobular growth connecting with epidermis & sometimes adjacent follicular external root sheath
•Small epithelial cells with often vacuolated cytoplasm and showing peripheral palisading
•Small nucleoli with vesicular nucleoli
•Rare or no mitoses
•No pleomorphism
•Eosinophilic thick basement membrane
•Overlying hyper- & parakeratosis
•Variable trichilemmal keratinization
•Trichilemmoma/inverted follicular keratosis overlap variant
•PAS +ve cytoplasm
•CK7, EMA , CEA & BerEP4 –ve
•CD34, p63 +ve










Desmoplastic trichilemmoma
Clinical features
•Presents as a solitary slowly growing <1.0 cm flesh colored or erythematous dome-shaped papule
•M>F, predilection for face but may occur on the scalp, neck, chest & vulva
•Non-syndromic
•May arise in nevus sebaceous
Histological features
•Typical trichilemmoma surrounding a densely, hyalinized collagenous region containing narrow epithelial strands sometimes mimicking a carcinoma
•The stroma contains glycogen & acid mucopolysaccharides & is DPAS+ve
•Stromal component is rich in type 1 collagen
•CK7, EMA , CEA & BerEP4 –ve
•CD34, p63 +ve

The diagnosis of both these tumors is nearly always readily apparent. The desmoplasia can result in suspicion of malignancy by the unwary. Trichilemmoma can be distinguished from poroma by the hyalinized thick basement membrane and absence of ducts. Desmoplastic trichilemmoma is distinguished from squamous carcinoma by the presence of typical trichilemmoma at the periphery and from trichilemmal carcinoma by the absence of pleomorphism & significant mitotic activity. Trichilemmal carcinoma does not show a pre-existent trichilemmoma. CD34 expression excludes squamous carcinoma
Leave a comment